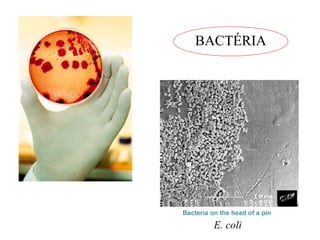
BACTÉRIA 
E. coli

O documento descreve a história da microbiologia, desde as primeiras observações de microrganismos por van Leeuwenhoek até as classificações modernas. Destaca os principais marcos como as disputas entre teorias sobre a geração espontânea, as descobertas de Pasteur e Koch, e as classificações propostas por Whittaker e Carl Woese baseadas nas características celulares e na obtenção de nutrientes respectivamente.